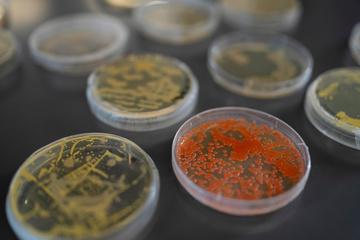

Undergraduate Degree Programs



![]()








Brent Nelson, PhD
Interim Dean, College of Science
Here at the Northeastern University College of Science we embrace the Good Power of Science to forge excellence in research and education. Science is all about solving real-world problems—finding new cures, creating cleaner energy, developing innovative materials, and discovering ways to protect our planet. It’s exciting, meaningful, and full of possibilities. A science degree can lead you in countless directions, opening doors to a wide range of careers and opportunities.
Every College of Science student gets the highest quality education. And unique to Northeastern, you’ll try out some future careers through your co-op experience.
Our graduates excel in every field, including medicine, research, policy, education, communications, finance, industry, management, business, and law.
The College of Science is a welcoming community, with a culture of respect—a place where every student belongs.

cos.northeastern.edu/bns
Undergraduate Degree
BS Behavioral Neuroscience
Combined Majors
BS Behavioral Neuroscience and Design
BS Behavioral Neuroscience and Philosophy
BSBioE Bioengineering and Behavioral Neuroscience
BS Computer Science and Behavioral Neuroscience
BS Data Science and Behavioral Neuroscience
BS Speech Language Pathology and Audiology and Behavioral Neuroscience
PlusOne Bachelor’s/Master’s Degrees
BS Behavioral Neuroscience/MS Bioinformatics
BS Behavioral Neuroscience/MS Applied Behavioral Analysis
BS Behavioral Neuroscience/MS Cell and Gene Therapies
Undergraduate Minor
Behavioral Neuroscience
Prime Medicin Featured Co-op Employers
The Behavioral Neuroscience (BNS) program combines multiple disciplines across the College of Science and beyond to understand how the behavior of humans and animals is controlled by physiological systems. The relationship between the brain’s activity and an organism’s behavior, both healthy and pathological, is examined at multiple levels of analysis, from how a nerve cell functions to how a facial expression conveys trust or fear.
BNS students gain a strong foundation in biology, psychology, physical sciences, and mathematics and statistics, and can customize their education to meet their specific interests by selecting from an extensive set of advanced neuroscience electives which focus on diverse specializations and current topics in the field. Advanced courses in Brain, Behavior and Immunity, Multidisciplinary Approaches to Motor Control, Neurobiology of Cognitive Decline, and others are unique offerings not typically found at peer institutions.
As some of medicine’s most promising frontiers for improving health explore the realms of human behavior, the BNS curriculum embodies the importance of this bio-psycho-social model of health and enhances the proficiency in scientific concepts, including mind-body connections, crucial for pre-health students to be successful in their training and practice.
At Northeastern, students receive strong support for their success, including personal attention in the classroom, academic and co-op advising, as well as peer tutoring.
To balance out the challenging course work, students thrive by engaging in BNS on campus with their peers via a variety of clubs and student organizations as well as our chapter of Nu Rho Psi, the national honor society in neuroscience.
AbbVie
Arbour Hospital
Beth Israel Deaconess Medical Center
Biogen, Inc.
Brigham and W
Cerevel Thera
Harvard Unive
McLean Hosp
Moderna
Neuro-Electro
Flanders-NER



cos.northeastern.edu/biochemistry
Understanding biochemical processes is a crucial step in problem-solving some of the world’s greatest challenges – disease, hunger, pollution. The success of vaccines to mitigate illnesses like smallpox, influenza, and coronavirus illustrates how important it is to have a deep understanding of how diseases work and how they can be targeted.
Students in the Biochemistry program in the College of Science explore how cell structure, chemical bonds, and energy transformations advance our understanding of the mechanisms of life and provide a strong foundation for a host of impactful careers in the life sciences.
After completing foundational scientific coursework in biochemistry, biology, chemistry, physics, and mathematics, our students take challenging courses that reflect many areas of biochemistry including neuroscience, bioorganic chemistry, stem cell and regenerative biology, microbial biotechnology, and systems biology and engineering.
At Northeastern, students receive strong support for their success, including personal attention in the classroom, academic and co-op advising, as well as peer tutoring.
On campus, students can engage in biochemistry with their peers through various clubs and organizations, including the Biochemistry Club, the American Medical Student Association, and the Women's Interdisciplinary Society of Entrepreneurship. These groups provide opportunities to interact with faculty, explore their research, and discover the many opportunities available to biochemistry majors. In fact, our students also travel each year to present their research at conferences, including those in Chicago, Philadelphia, Orlando, Seattle, and more.

Undergraduate Degrees
BS Biochemistry
Combined Majors
BSBioE Bioengineering and Biochemistry
BSChE Chemical Engineering and Biochemistry
BS Data Science and Biochemistry
PlusOne Bachelor’s/Master’s Degrees
BS Biochemistry/MS
Bioinformatics
BS Biochemistry/MS
Biotechnology
BS Biochemistry/MS Cell and Gene Therapies
BS Biochemistry/MS
Chemistry
Undergraduate Minor
Biochemistry
Featured Co-op Employers
Alnylam Pharmaceuticals
BioNTech
Boston Children’s Hospital
Brigham and Women’s Hospital
Dana-Farber Cancer Institute
Massachusetts General Hospital
Moderna
Tango Therapeutics
Takeda Pharmaceuticals

Undergraduate Degrees
BS Biology
BS Cell and Molecular Biology
Combined Majors
BS Biology and English
BS Biology and Mathematics
BS Biology and Political Science
BS Computer Science and Biology
BS Data Science and Biology
PlusOne Bachelor’s/Master’s Degrees
MS Bioinformatics
MS Biotechnology
MS Cell and Gene Therapies
Undergraduate Minors
Biology
Cell and Molecular Biology
Science Writing
Featured Co-op Employers
Beam Therapeutics
Beth Israel Lahey Health
Brigham and Women’s Hospital
Broad Institute of MIT and Harvard
Harvard Medical School
Massachusetts General Hospital
Moderna
Pfizer
Sana Biotechnology
Sanofi
Global Learning Opportunities
Life Sciences at the University of Dundee (Scotland)
Semester In-Life Science in Action at The American College of Thessaloniki (Greece)
Semester In Oakland for PreMed and PreHealth students
In the Department of Biology, our scientific expertise spans the realm of the biological sciences to drive advances in medicine and healthcare, biotechnology, education, and public policy. Students studying biology develop a broad understanding of the organization and processes of life, from molecules and cells through tissues and organs, to populations, ecosystems, and evolution.
Through challenging coursework, experiential learning opportunities, and unique study abroad programs, students develop a deep understanding of biological principles, as well as innovative advances in the biomedical and life sciences. Northeastern biology students will become leaders in these efforts as they learn to create and apply new knowledge and build their scientific and technical skill sets.
As the curriculum progresses, students select from electives in a wide array of sub-disciplines that include
Genomics
Cell and Molecular Biology
Microbiology
Physiology and Systems Biology
Developmental and Stem Cell Biology
Organismal Biology
At Northeastern, students receive strong support for their success. This includes academic, co-op, pre-health, and career advising, as well as peer tutoring.
Students can engage in biology on campus with their peers through various clubs and organizations, including the Biology Club, the American Medical Student Association, and the Undergraduate Research Club. These groups provide opportunities to interact with faculty, explore their research, and discover the many opportunities available to biology majors.



As new generations of chemists harness the nature of matter, their discoveries will improve our health, our environment, and our lives. The impact of CRISPR and gene editing on novel medicines, the directed evolution of enzymes and protein design on life-saving vaccines, and the development of renewable energy sources, such as lithium-ion batteries, on the preservation of our environment represent just a fraction of the possibilities.
The College of Science Chemistry program, through stimulating and supportive real-world preparation and research, provides students with the best foundation to achieve their goals, whether they plan to attend graduate school, pursue careers in health or medicine, or enter the global workforce.
Required courses for chemistry students are taught by full-time PhD-holding faculty. As chemistry majors move further into the program, class sizes get smaller and lab sessions become more intensive. Our 5:1 student-faculty ratio provides students with an opportunity to make deep connections with faculty members and build relationships with research advisors and mentors.
While chemistry majors take some of the most challenging courses at Northeastern, there is plenty of support for success, including academic and co-op advising. Every incoming student is paired with a mentor – a relationship that can continue well into the mentee’s career – and has resources available to them like ChemCentral, academic support with chemistry graduate students.
On campus, students can become involved in chemistry with their peers via a variety of clubs and student organizations. Our award-winning student chapter of the American Chemical Society hosts top speakers (including two Nobel laureates), promotes career development discussion among peers, coordinates community outreach, and provides opportunities to travel to professional society meetings.

Undergraduate Degree
BS Chemistry*
*with options for concentrations in Chemical Biology or Materials Chemistry
Combined Majors
BS Data Science and Chemistry
BS Environmental and Sustainability Sciences and Chemistry
PlusOne Bachelor’s/Master’s Degrees
BS/MS Chemistry
BS Biochemistry/MS Chemistry
BS Chemistry/MS Biotechnology
Undergraduate Minors
Chemistry
Environmental Chemistry
Featured Co-op Employers
908Devices
Advent Technologies, Inc.
Boston Children’s Hospital
Dana-Farber Cancer Institute
Draper Laboratory
Harvard Medical School
Living Proof, Inc.
Moderna
Takeda Pharmaceuticals


Undergraduate Degree
BS Linguistics
Combined Majors
BS American Sign Language and Linguistics
BA Linguistics and Communications Studies
BS Computer Science and Linguistics
BS Linguistics and Cultural Anthropology
BA Linguistics and English
BS Linguistics and Psychology
BS Data Science and Linguistics
BS Linguistics and SpeechLanguage Pathology and Audiology
Undergraduate Minor
BA Spanish and Linguistics Linguistics
Featured Co-op Employers
Boston College Language Laboratory
Massachusetts State Archives
National Geographic Learning
Perkins School for the Blind Psycholinguistics and Language Development Group
University of Kaiserslautern (Germany)
Students studying linguistics explore, investigate, and discover the fundamental principles and concepts that underlie the one feature that makes humans so unique: language!
The Linguistics program in the College of Science equips students with the tools to examine and better understand the striking complexity of linguistic knowledge, appreciate the remarkable diversity of linguistic structure, and unravel a bit of the mystique surrounding this critical facet of the human experience.
Central to the study of linguistics is the structure of language: sounds and sound patterns (Phonetics and Phonology) words (Morphology) phrases and sentences (Syntax) meaning (Semantics)
This structural knowledge in turn allows students to better understand the social context of language, how it evolves over time, how it is acquired, and how it is processed in the brain.
Linguistics courses, taught by faculty passionate about the field, focus on developing the skills needed to build a solid foundation for nearly any type of future profession or graduate-level study:
Pattern identification
Data interpretation
Independent thinking
Abstract reasoning
Persuasion and evidence
Scientific writing skills
Oral presentation skills
At Northeastern, students receive strong support for their success, including personal attention in the classroom, academic and co-op advising, as well as peer tutoring.
Student organizations, such as the Linguistics Club, offer opportunities to connect with like-minded individuals and interact with faculty, explore their research, and discover the many opportunities available to linguistics majors.



Students in the Marine and Environmental Sciences (MES) program work towards cultivating the knowledge and understanding necessary to develop solutions to the world's most pressing environmental challenges including overexploitation of natural resources, habitat destruction, climate change, and sea-level rise. The MES curriculum is designed around four majors that provide students with comprehensive knowledge in coupled human and natural systems, drawing on courses across the physical, natural, and social sciences and humanities.
Environmental and Sustainability Sciences majors explore multidisciplinary approaches to solving environmental challenges and can pursue one of four concentration areas: Environment and Society, Sustainable Planning and Development, Conservation, Restoration, and Management, and Earth, Oceans, and Environmental Change.
Environmental Studies students build a critical foundation in the scientific and human aspects of environmental systems, with a focus on developing skills for environmental careers. They can concentrate in one of five areas, designed to cover the breadth of areas where people and the environment intersect: public health, environmental justice, environmental law, visualizations and storytelling, and the green economy.
Ecology and Evolutionary Biology majors focus on the foundational science underlying the evolution and ecology of natural systems. The coursework, which also fulfills pre-health requirements, exposes students to cutting edge fields, such as evolutionary genomics and disease ecology.
Marine Biology students obtain a solid foundation in marine biology, with flexibility to explore ocean and coastal processes, marine biogeochemistry, the ecology and evolution of marine organisms, and the ocean’s role and responses in global change.
MES students often conduct internships, co-op, or capstone course at the university’s Marine Science Center in Nahant, MA. There’s a strong support for their success, including personal attention in the classroom, academic and co-op advising, and through services like the MES Peer Mentoring Program, which connects new students with upperclass students.
On campus, students can become involved in marine biology and environmental science with their peers via a variety of clubs and student organizations, such as the Marine Biology Club, the TERRA Society, and Slow Food NU.



Undergraduate Degrees
BS Environmental and Sustainability Sciences
BA Environmental Studies
BS Ecology and Evolutionary Biology
BS Marine Biology
Combined Majors
BS Computer Science and Environmental and Sustainability Sciences
BS Environmental and Sustainability Sciences and Economics
BS Data Science and Environmental and Sustainability Sciences
BS Environmental and Sustainability Sciences and Chemistry
BA Environmental Studies/Political Science
BA Environmental Studies and International Affairs
PlusOne Bachelor’s/Master’s Degrees
BS/MS Marine Biology
BS/MS Environmental Science and Policy
BA/MS Environmental Science and Policy
BS/MS Climate Science and Engineering
Undergraduate Minors
Ecology and Evolutionary Biology
Environmental and Sustainability Sciences
Environmental Studies
Geosciences
Marine Sciences
cos.northeastern.edu/mathematics
Undergraduate Degrees
BS Mathematics
BA Mathematics
Combined Majors
BS Biology and Mathematics
BS Computer Science and Mathematics
BS Data Science and Mathematics
BS Design and Mathematics
BS Economics and Mathematics
BS Mathematics and Business Administration
BS Mathematics and Philosophy
BS Mathematics and Physics
BS Mathematics and Political Science
BS Mathematics and Psychology
BS Mathematics and Sociology
PlusOne Bachelor’s/Master’s Degrees
BS Mathematics/MS Applied Mathematics
Undergraduate Minor
Mathematics
Featured Co-op Employers
Analysis Group
Coverys
Fidelity
John Hancock
Liberty Mutual
Mathnasium
Massachusetts Bay Transportation Authorit (MBTA)
Milliman
MIT Lincoln Laboratorie
The College of Science mathematics degree prepares students to face the mathematical challenges of the world. Students develop strong mathematical and problem-solving skills, preparing them to achieve their goals in virtually all fields of human endeavor, including business, the arts, and the social sciences.
Our mathematics curriculum is designed to be both comprehensive and flexible, offering students a wide range of courses in pure and applied mathematics areas. Math majors may pursue either a Bachelor of Science or a Bachelor of Arts. Math majors pursuing a Bachelor of Arts take fewer math courses but an increased number of general electives and often choose careers in primary or secondary education.
At Northeastern, students receive strong support for their success, including personal attention from instructors in the classroom, academic and co-op advising, as well as peer tutoring.
Students can engage in mathematics activities on campus with their peers through various clubs and organizations, including the Math Club, Actuarial Club, MathEMA (a peer mentoring math club), and the Association for Women in Mathematics. These groups provide opportunities to interact with faculty and graduate students, learn about research including undergraduate research, and discover the many opportunities available to math majors.




In the Department of Physics, students explore the fundamental physical principles that govern natural phenomena ranging from the smallest scales of the quantum world to atoms, molecules, organic systems, and cosmic scales of the universe.
Our students and scientists specialize in many exciting areas of theoretical and experimental research, including quantum materials and nanotechnology, biophysics and the study of complex systems, elementary particle physics and astronomy, and research in innovative education.
Physics students benefit from small class sizes typically taught by full-time PhDbearing faculty. Our 5:1 student-faculty ratio provides students an opportunity to make deep connections with faculty members and build relationships with advisors and mentors. Laboratory courses provide hands-on experiences with sophisticated physics instruments and advanced experimental techniques.
A vibrant research-driven environment fosters diverse opportunities for publishable research and presentations at prestigious academic meetings, such as American Physical Society, Biophysical Society, and Materials Research Society.
At Northeastern, students receive strong support for their success, including personal attention in the classroom, academic and co-op advising, as well as peer tutoring.
Undergraduate Minors cos.northeastern.edu/physics
On campus, students can become involved in physics with their peers via a variety of clubs and student organizations, such as the Society of Physics Students. These groups provide opportunities to interact with faculty, explore their research, and discover the many opportunities available to physics majors.

Undergraduate Degrees
BS Physics*
BS Applied Physics*
BS Biomedical Physics
*with an option for Astrophysics concentration
Combined Majors
BS Computer Science and Physics
BS Data Science and Physics
BS Mathematics and Physics
BS Physics and Music with Concentration in Music Technology
BS Physics and Philosophy
BSChE Chemical Engineering and Physics
BSCmpE Computer Engineering and Physics
BSEE Electrical Engineering and Physics
BSME Mechanical Engineering and Physics


Astrophysics
Physics
Air Force Research Laboratory Bose
CERN
Harvard Center for Astrophysics
MGH Martinos Center for Biomedical Imaging
MIT Lincoln Laboratories
MKS Instruments
NU Network Science Institute
Photo Diagnostic Systems
Radiation Monitoring Devices
Undergraduate Degree
BS Psychology
Combined Majors
BS American Sign Language and Psychology
BS Business Administration and Psychology
BS Computer Science and Psychology
BS Criminal Justice and Psychology
BS Data Science and Psychology
BS Economics and Psychology
BS Health Science and Psychology
BS Human Services and Psychology
BS Linguistics and Psychology
BS Mathematics and Psychology
BS Psychology and Design
BS Psychology and Music
BS Psychology and Theatre
Undergraduate Minor
Psychology
Featured Co-op Employers
Arbour Hospital
Beth Israel Deaconess Medical Center
Boston Medical Center
Brigham and Women’s Hospital
Goodwin Proctor LLP
Mass General Brigham McLean Hospital
Perkins School for the Blind
Walden Behavioral Care
The College of Science Psychology program works to explore the deepest inner workings of our brains and uncover why we do what we do. Psychology majors study the science of mind, brain, and behavior. Our research-based education offers a broad range of interests in basic and applied psychology with interdisciplinary exploration and highly flexible learning experiences.
Our students engage in academic course work and experiential learning opportunities that span the breadth of psychology, as well as in-depth explorations that meet their own specific interests. Students have the flexibility to take a wide range of courses, including:
Developmental Psychology
Biological Psychology
Cognition
Love and Hate
Drugs and Behavior
Sports Psychology
Clinical Neuroscience
Brain, Behavior, and Immunity
Neuropsychology of Fear
The Moral Mind
Psychopharmacology
Psychology of Language
Cognitive Development
A solid scientific background in psychology helps prepare students for a wide range of careers in such domains as education, business, public service, or research. It also provides a strong foundation for graduate and professional study in psychology, cognitive science, behavioral neuroscience, law, and medicine.
At Northeastern, students receive strong support for their success, including personal attention in the classroom, academic and co-op advising, as well as peer tutoring.
On campus, students can become involved in psychology with their peers on campus via a variety of clubs and student organizations, such as the Northeastern Undergraduate Researchers of Neuroscience, Active Minds, PsyClub, and Psi Chi, the International Honor Society in Psychology. These groups provide opportunities to interact with faculty, explore their research, and discover the many opportunities available to psychology majors.



The Northeastern PreMed and PreHealth Advising Program provides individualized advising resources to undergraduate students from all disciplines on their pathway to medical school, dental school, physician assistant school, podiatry school, optometry school, and veterinary school.
70%
PreMed and PreHealth students are from the College of Science
79% 5-year average medical school acceptance rate (COS 2021-25)
Learn more: undergraduate.northeastern.edu/prehealth/
2X National average medical school acceptance

Clinical and research co-ops
Global experiences
Community engagement
Pre-Medical (MD/DO)
Pre-Dental
Pre-Optometry
Pre-Physician Assistant
Pre-Podiatry
Pre-Veterinary

Studying in a top-tier R1 research university, Northeastern students find ample opportunities - as early as their first year - to engage in key research areas including health, security, and sustainability, through co-op placements, faculty labs, or individual group projects.
200+ Research Labs and Groups
15 Interdisciplinary Research Centers and Institutes
College of Science students excel in earning awards that offer financial and academic support to those seeking to conduct original research of their own design.
28
35 Scholar Independent Research Fellowship Awards 6 years in row of Barry Goldwater Scholarship recipients
Explore a range of industry opportunities by typically doing two six-month co-ops in different organizations
Pursue co-ops in research environments
Integrate classroom and workplace learning
Create valuable networks of mentors and colleagues
Clarify short and long terms professional, academic, and personal goals
Add professional work experience to be a soughtafter candidate for postgraduate programs and employment
Students typically don’t take classes while on co-op (so no tuition paid); in fact, most co-ops pay students for their work
Experiential learning has been the hallmark of a Northeastern education since our founding. This type of learning enables students to acquire a deeper, realworld perspective while they explore prospective career paths and prepare for graduate school, medical school, or employment. Experience-based learning happens through research, community service, and global experiences and studies abroad. But the heart of this approach is the university’s internationally recognized cooperative education program.
Students may participate in the co-op program after completing three academic semesters and can alternate periods of academic study with six-month periods of work experience related to the major and/or career goals.
Co-op advisors help students to plan their co-op experiences and keep them on track for graduation.

Northeastern University partners with over 4,000 co-op employers in the US and in 149 countries around the world.



Northeastern is a global university with flexible opportunities for undergraduates to experience various program locations and partnerships worldwide.
Starting at the Northeastern University Boston campus, first-year students will have the opportunity to be immersed in a diverse, global, and thriving campus environment in a city full of history, industry, and educational opportunities. You will have all the advantages of a small campus feel in a big city and the benefits of small classes and connections within a large university.
Northeastern University Oakland students can pursue a variety of interdisciplinary degree programs positioned at the intersection of technology, healthcare, science, and business. After the first year, students have the opportunity to transition to Northeastern's Boston campus or choose to complete their studies in the Bay Area.
The N.U.in Program is a first-semester global experience rooted in Northeastern’s core belief that students should be engaged citizens of the world. N.U.in stud begin their studies as a cohort at one of our program locations before transitioning to the Boston campus in January for the second semester.
In the London Scholars Program students spend Fall and Spring semesters studying in London. During their second year and beyond, London Scholars have the opportunity to study on Northeastern’s Boston campus or continue explore global program offerings.
New York City Scholars begin their journey at the Marymount Manhattan College campus in Manhattan as a cohort of fellow first-year Northeastern students. In their second year and beyond, NYC Scholars will study on Northeastern's Boston campus and have the opportunity to continue to explore global program offerings.
Regardless of a student’s first year entry program into Northeastern, they will have comprehensive academic advising support.
Dialogue of Civilizations Programs are offered during either the Summer 1 or Summer 2 semesters. Students will learn about a specific topic or course subject on location, spending 30 days abroad with a faculty leader from Northeastern.



The Study Abroad Program is offered during the Fall, Spring, Summer 1, or Summer 2 semesters. Students take classes and earn Northeastern credit at a university abroad.
The Co-op Program includes exciting opportunities abroad. NU’s global presence spans all seven continents allowing our co-op employer partners and students alike to gain access in tapping the increasingly competitive job market on a global stage.
The Semester In Program offers semester-long immersive experience where undergraduate students engage in industry site-visits, alumni and networking events, guest lectures, and opportunities for internships or co-op in the region, all while taking courses at specific Northeastern global campuses.

COS Entrepreneurship Speaker Series
COS Entrepreneurship Workshops
Science Connects to Innovation Scholarship Program
In the College of Science, students are encouraged to unlock their creativity and build problem-solving and leadership skills to fuel entrepreneurial learning.
Our Science Connects to Innovation Program empowers undergraduate science students through education, resources, and networks to create entrepreneurial solutions—spanning cleaner energy, eco-friendly pesticides, potential anticancer compounds, sustainable foods, and high-tech assistive devices.




Northeastern offers over 600 student clubs and organizations, providing opportunities to meet new people, explore hobbies, and get involved on campus. These include leadership-focused groups like the Student Government Association, academic and professional societies, athletic clubs, performing arts groups, and cultural organizations, allowing students to connect, develop skills, and network with professionals in their fields.

COS Student Clubs and Organizations

